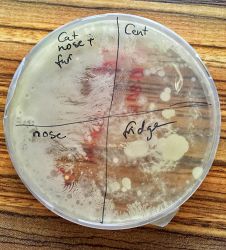
Day 7 - Full dish
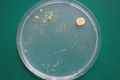
Plasmodium extracted from another living organism

/Physarum Polycephalum and light
/Helpfull Resources for culturing
1st class: 16. Oktober 2018 - Introduction
Summary
General introduction to working in the bio lab. Preparing the first testing Agar-Plates for bacterial growth in a petri dish:
- petri dishes where filled with 15 ml of an LBP (Baird-Parker liquid) Medium with Agar Agar
- cooling down
- inoculateing with different surface smear
- In my case: human nose (inside), cat nose (outside) and fur, fridge glass surface and 1 cent coin
- left with room temperature for the following days
First culture medium
As described obove the filled petri dishes are now beeing observed for the following days.
Gallery
Breeding day 7 - closer look
Somehow I got the impression that the petri dishes weren't sterile as after 7 days almost the full dish is covered with a white film. You can only guess by slightly different colors where I initially inoculated the dish. Something seems to grow over the originally inoculated sections. See below some close ups. In the section of the example I took from my nose, a small yellow dot appears. I think this is what was intended to be growing. The rest just looks almost the same.
Gallery
DIY Microscope Test
What was done?
- extracted converging lens from a laser pointer
- attached to iPhone SE back camera
Results
- adding some filters to increase contrast und depth
Literature
László Moholy-Nagy
From material to architecture (Full text english)
(Source: https://monoskop.org/images/a/af/Moholy-Nagy_Laszlo_The_New_Vision_and_Abstract_of_an_Artist.pdf, page 14 - 19)
Von Material zu Architektur (Volltext deutsch)
(Quelle: https://monoskop.org/images/b/b5/Moholy-Nagy_Laszlo_Von_Material_zu_Architektur.pdf, Seite 10 - 18)
Dimitris Papadopoulis
Generation M - Matters, Makers, Microbiomes (source: https://dialnet.unirioja.es/descarga/articulo/4903686.pdf)
2nd class: 23. October 2018 - Ethics - Microscopy - Physarum Polycefalum
Summary
Paper reading
We first discussed two papers we read at home. One from Moholy-Nagy and the other one from Dimitris Papadopoulos. Moholy Nagy refers to the primitive human being from back in the ages and how he considered the human beeing back in the age when he lived. A lot of criticism and what effects those negative sides of specialized humans have versus paper number two to be considered more as a manifest with no critic or political views.
Ethics
Today we've been also talking about ethical questions that come up while working living tissues. To sum it up: At all times you always need to be aware of working with living organisms. Be respectful and know that you are always responsible for what you do and that, in the end, you have to deal with the consequences.
Practical Part
Another hands on in the Lab. I decided to prepare a new Agar medium to grow some Physarum Polycephalum.
Physarum Polycephalum
Physarum is a slime mold that is often used as a model for testing in the lab as it is well researched and known. See below documentation of the whole process. It is also easy to observe without magnification. (see wikipedia)
Documentation
Setting
This is my first try with this organism. I want to get in touch with it and feel more comfortable working with it. So I need to know how it behaves and interacts with its environment. After the first run I will have another one with more specific adjustments, such as taxis based on different environment factors (i. g. chemicals, sound, movement, nutrients). But first I used the most basic setting:
- 100 ml tab water
- 2g Agar
- mix Agar with water and microwave it till it starts to boil
- fill the petri dishes and let it cool down till its gel
- extract parts from another culture of physarum and attach it to the medium
Thats what I did. I prepared two petri dishes. One with a plasmodial form and the other one with sclerotial form. To use the sclerotium I added some water to "wake" it up from its dormant state. I took it home and took a few pictures:
Day 1: 23. Oktober 2018, 21:45
I fed the plasmodium 1 (alive already) with oats at one border (I placed the organism in the middle) and with wheatgems at another border to see what happens. Plasmodium 2 (dormant before) was also placed in the middle but fed only with wheatgems. After feeding I placed them in complete darkness with 20°C.
Day 2: 24. Oktober 2018, 10:45
- Extraction from plasmodial state for cultivation - Growth 2nd day
Not much rich growing and reaching out for food overnight. I guess thats because the organism had access to food at all times. So from this state on I can't guess if Physarum preferes the oats or the wheatgems. Lets see in a few days.
- Extraction from sclerotial state for cultivation - Growth 2nd day
Rich growing overnight. As result of beeing in domant state for some time, I guess. It also seems like it feels attracted by the wheatgems. Also need to state that it only got one source of food.
Day 3: 25. Oktober 2018, 12:00
- Extraction from plasmodial state for cultivation - Growth 3rd day
Not that much change. Physarum found the source of food and is moving in the dish but is not as active as Plasmodium 2. As it had two food sources it chose for the wheatgems. Placed some smaller oat parts in the dish in another corner. Let's see what happens. Still kept in complete darkness in my closet covered with towels.
- Extraction from dormant (sclerotium) state for cultivation - Growth 3rd day
Much more active than Plasmodium 1. Physarum 2 is moving a lot and much faster than Plasmodium 1. Moved over the food source (wheatgems) to the edge of the dish. Added some small oat parts to see if Physarum moves towards the new food source. Still kept in complete darkness in my closet covered with towels.